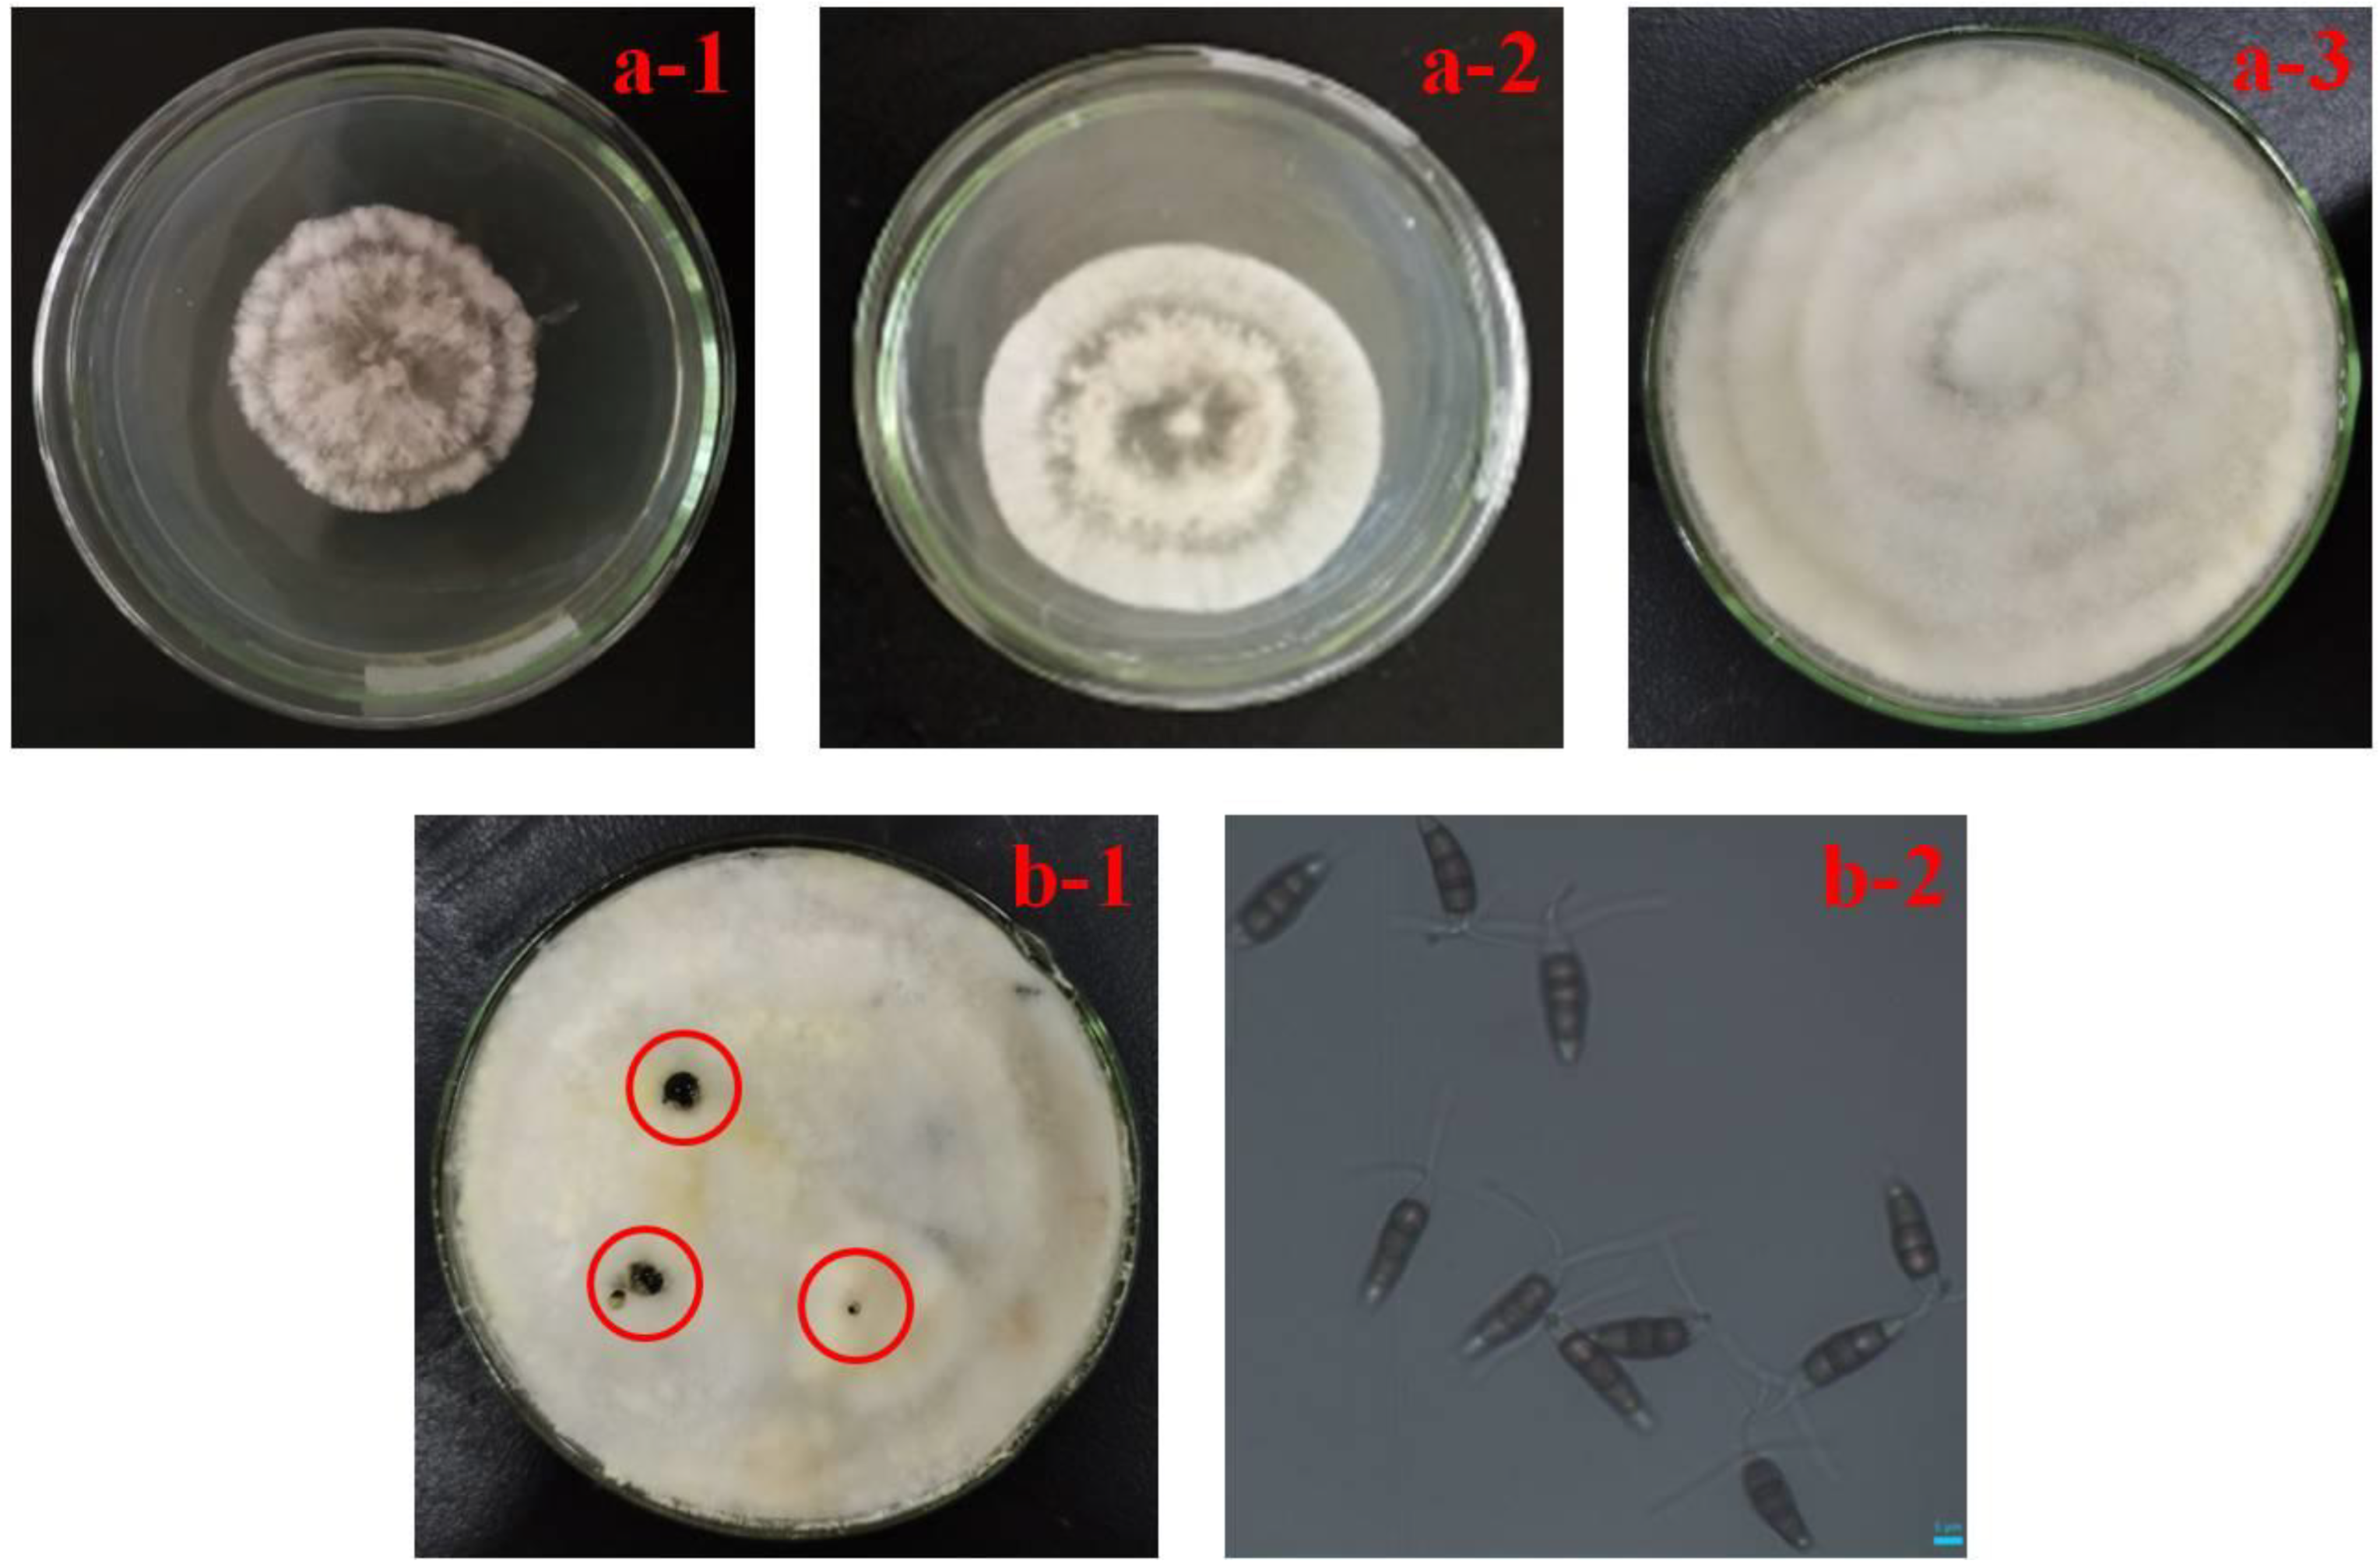
Horticulturae 08 00190 g002 Horticulturae 08 00190 g002

First Isolation and Identification of Neopestalotiopsis clavispora Causing Postharvest Rot of Rosa sterilis and Its Control with Methyl Jasmonate and Calcium Chloride
Abstract
1. Introduction
2. Materials and Methods
2.1. Sample Collection
2.2. Pathogen Isolation and Morphological Characterization
2.3. Preparation of Spore Suspension
2.4. Pathogenicity Test
2.5. DNA Extraction, PCR Amplification and ITS Sequence Analysis
2.6. Fruits and Treatment
2.7. Inhibitory Effect of MeJA or CaCl2 Alone and Their Combination on Artificially Inoculated Fruit
2.7.1. Determination of Disease Incidence
2.7.2. Assay of Defense-Related Enzyme Activity
2.7.3. Determination of Hardness and Vitamin C Content
2.8. Statistical Analysis
3. Results
3.1. Typical Symptoms of Rot Fruit and Morphological Identification of Pathogen
3.2. Pathogenicity
3.3. rDNA-ITS Sequence Analysis of Pathogen
3.4. Effects of Different Treatments in Controlling Decay on Artificially Inoculated R. sterilis Fruit
3.5. Effect of Different Treatments on the Activity of Defense-Related Enzymes
3.6. Effect of Different Treatments on Hardness and Vitamin C Content
4. Discussion
5. Conclusions
Supplementary Materials
Author Contributions
Funding
Institutional Review Board Statement
Informed Consent Statement
Data Availability Statement
Acknowledgments
Conflicts of Interest
References
- Li, J.L.; Quan, W.X.; Li, C.C.; Shi, D.H.; Hu, J.W.; Jin, J.; Ruan, W. Effects of ecological factors on content of flavonoids in Rosa sterilis from different Karst areas of Guizhou, SW China. Pak. J. Bot. 2018, 50, 1125–1133. [Google Scholar]
- Wen, X.P.; Deng, X.X. Characterization of genotypes and genetic relationship of cili (Rosa roxburghii) and its relatives using RAPD markers. Chin. J. Agr. Biotech. 2003, 11, 605–611. [Google Scholar] [CrossRef]
- Wen, X.P.; Pang, X.M.; Deng, X.X. Characterization of genetic relationships of Rosa roxburghii Tratt and its relatives using morphological traits, RAPD and AFLP markers. J. Hortic. Sci. Biotech. 2004, 79, 189–196. [Google Scholar] [CrossRef]
- Liang, G.-Y.; Gray, A.I.; Waterman, P.G. Pentacyclic triterpenes from the fruits of Rosa sterilis. J. Nat. Prod. 1989, 52, 162–166. [Google Scholar] [CrossRef]
- He, J.Y.; Zhang, Y.H.; Ma, N.; Zhang, X.L.; Liu, M.H.; Fu, W.M. Comparative analysis of multiple ingredients in Rosa roxburghii and R. sterilis fruits and their antioxidant activities. J. Funct. Food. 2016, 27, 29–41. [Google Scholar] [CrossRef]
- Liu, M.H.; Zhang, Q.; Zhang, Y.H.; Lu, X.Y.; Fu, W.M.; He, J.Y. Chemical analysis of dietary constituents in Rosa roxburghii and Rosa sterilis fruits. Molecules 2016, 21, 1024. [Google Scholar] [CrossRef]
- Luo, X.L.; Dan, H.L.; Li, N.; Li, Y.H.; Zhang, Y.J.; Zhao, P. A new catechin derivative from the fruits of Rosa sterilis SD. Shi. Nat. Prod. Res. 2017, 31, 2239–2244. [Google Scholar] [CrossRef]
- Shi, J.-F.; Sun, C.-Q. Isolation, identification, and biocontrol of antagonistic bacterium against Botrytis cinerea after tomato harvest. Braz. J. Microbiol. 2017, 48, 706–714. [Google Scholar] [CrossRef]
- Zhang, S.W.; Zheng, Q.; Xu, B.L.; Liu, J. Identification of the fungal pathogens of postharvest disease on peach fruits and the control mechanisms of Bacillus subtilis JK-14. Toxins 2019, 11, 322. [Google Scholar] [CrossRef]
- Lorenzini, M.; Zapparoli, G. Identification of Pestalotiopsis bicilita, Diplodia seriata and Diaporthe eres causing fruit rot in withered grapes in Italy. Eur. J. Plant Pathol. 2018, 151, 1089–1093. [Google Scholar] [CrossRef]
- Pan, L.Y.; Zhao, X.Y.; Chen, M.; Fu, Y.Q.; Xiang, M.L.; Chen, J.Y. Effect of exogenous methyl jasmonate treatment on disease resistance of postharvest kiwifruit. Food Chem. 2020, 305, 125483. [Google Scholar] [CrossRef] [PubMed]
- He, J.H.; Ma, L.J.; Wang, D.J.; Zhang, M.Y.; Zhou, H.L. Ferulic acid treatment reinforces the resistance of postharvest apple fruit during gray mold infection. J. Plant Pathol. 2019, 101, 503–511. [Google Scholar] [CrossRef]
- Pan, T.T.; Sun, D.-W.; Pu, H.B.; Wei, Q.Y.; Xiao, W.; Wang, Q.J. Detection of A. alternata from pear juice using surface-enhanced Raman spectroscopy based silver nanodots array. J. Food Eng. 2017, 215, 147–155.10. [Google Scholar] [CrossRef]
- Guo, M.J.; Wang, Q.T.; Cheng, Y.H.; Hou, C.L. Identification of Aspergillus tubingensis causing pomegranate fruit rot in China. Australas. Plant Path. 2021, 50, 233–240. [Google Scholar] [CrossRef]
- Palou, L.; Smilanick, J.L. Postharvest Pathology of Fresh Horticultural Produce; CRC Press: New York, NY, USA, 2020; pp. 375–406. [Google Scholar]
- Diaz, G.A.; Latorre, B.A.; Ferrada, E.; Lolas, M. Identification and characterization of Diplodia mutila, D. seriata, Phacidiopycnis washingtonensis and Phacidium lacerum obtained from apple (Malus x domestica) fruit rot in Maule Region, Chile. Eur. J. Plant Pathol. 2019, 153, 1259–1273. [Google Scholar] [CrossRef]
- Jiang, J.J.; Zhai, H.Y.; Li, H.N.; Wang, Z.H.; Chen, Y.S.; Hong, N.; Wang, G.; Chofong, G.N.; Xu, W. Identification and characterization of Colletotrichum fructicola causing black spots on young fruits related to bitter rot of pear (Pyrus bretschneideri Rehd.) in China. Crop. Prot. 2014, 58, 41–48. [Google Scholar] [CrossRef]
- Oo, M.M.; Oh, S.K. Identification and characterization of new record of grape ripe rot disease caused by Colletotrichum viniferum in Korea. Mycobiology 2017, 45, 421–425. [Google Scholar] [CrossRef]
- Zhu, J.Z.; Li, C.X.; Zhang, C.J.; Wang, Y.; Li, X.G.; Zhong, J. Fusarium solani causing fruit rot of peach (Prunus persica) in Hunan, China. Crop. Prot. 2019, 122, 171–174. [Google Scholar] [CrossRef]
- Michailides, T.J.; Thomidis, T. First report of Phomopsis amygdali causing fruit rot on peaches in Greece. Plant Dis. 2006, 90, 1551. [Google Scholar] [CrossRef]
- Li, L.; Pan, H.; Chen, M.Y.; Zhang, S.J.; Zhong, C.H. Isolation and identification of pathogenic fungi causing postharvest fruit rot of kiwifruit (Actinidia chinensis) in China. J. Phytopathol. 2017, 165, 782–790. [Google Scholar] [CrossRef]
- Zhou, Y.; Gong, G.S.; Cui, Y.L.; Zhang, D.X.; Chang, X.L.; Hu, R.P.; Liu, N.; Sun, X. Identification of Botryosphaeriaceae species causing kiwifruit rot in sichuan province, China. Plant Dis. 2015, 99, 699–708. [Google Scholar] [CrossRef] [PubMed]
- Espinoza, J.G.; Briceno, E.X.; Keith, L.M.; Latorre, B.A. Canker and twig dieback of blueberry caused by Pestalotiopsis spp. and a Truncatella sp in Chile. Plant Dis. 2008, 92, 1407–1414. [Google Scholar] [CrossRef] [PubMed]
- Chamorro, M.; Aguado, A.; De los Santos, B. First report of root and crown rot caused by Pestalotiopsis clavispora (Neopestalotiopsis clavispora) on strawberry in Spain. Plant Dis. 2016, 100, 1495. [Google Scholar] [CrossRef]
- Wang, K.T.; Jin, P.; Han, L.; Shang, H.T.; Tang, S.S.; Rui, H.J.; Duan, Y.; Kong, F.; Kai, X.; Zheng, Y. Methyl jasmonate induces resistance against Penicillium citrinum in Chinese bayberry by priming of defense responses. Postharvest Biol. Tec. 2014, 98, 90–97. [Google Scholar] [CrossRef]
- Wang, K.T.; Jin, P.; Shang, H.T.; Zheng, Y.H. Effect of methyl jasmonate in combination with ethanol treatment on postharvest decay and antioxidant capacity in Chinese bayberries. J. Agric. Food Chem. 2010, 58, 9597–9604. [Google Scholar] [CrossRef]
- Chen, J.P.; Zou, X.; Liu, Q.; Wang, F.; Feng, W.; Wan, N. Combination effect of chitosan and methyl jasmonate on controlling Alternaria alternata and enhancing activity of cherry tomato fruit defense mechanisms. Crop. Prot. 2014, 56, 31–36. [Google Scholar] [CrossRef]
- Wang, S.-Y.; Shi, X.-C.; Liu, F.-Q.; Laborda, P. Effects of exogenous methyl jasmonate on quality and preservation of postharvest fruits: A review. Food Chem. 2021, 353, 129482. [Google Scholar] [CrossRef]
- Gupta, N.; Jawandha, S.K.; Gill, P.S. Effect of calcium on cold storage and post-storage quality of peach. J. Food Sci. Technol.-Mysore 2011, 48, 225–229. [Google Scholar] [CrossRef]
- Li, L.; Ban, Z.J.; Li, X.H.; Xue, T. Effect of 1-methylcyclopropene and calcium chloride treatments on quality maintenance of ’Lingwu Long’ Jujube fruit. J. Food Sci. Technol.-Mysore 2014, 51, 700–707. [Google Scholar] [CrossRef][Green Version]
- Zhao, J.; Liu, W.C.; Liu, D.W.; Lu, C.G.; Zhang, D.P.; Wu, H.L.; Dong, D.; Meng, L. Identification and evaluation of Aspergillus tubingensis as a potential biocontrol agent against grey mould on tomato. J. Gen. Plant Pathol. 2018, 84, 148–159. [Google Scholar] [CrossRef]
- Xie, G.F.; Wang, L.R.; Fan, K.X.; Liu, N.; Liu, Y.L.; Zhao, Z.B. Postharvest 1-methylcyclopropene treatments maintain the quality of Rosa sterilis D. shi during storage. Food Sci. Technol. 2020, 40, 89–94. [Google Scholar] [CrossRef]
- Biju, C.N.; Peeran, M.F.; Gowri, R. Identification and characterization of Neopestalotiopsis clavispora associated with leaf blight of small cardamom (Elettaria cardamomum Maton). J. Phytopathol. 2018, 166, 532–546. [Google Scholar] [CrossRef]
- Jayawardena, R.S.; Zhang, W.H.; Liu, M.H.; Maharachchikumbura, S.S.N.; Zhou, Y.; Huang, J.B.; Nilthong, S.; Wang, Z.; Li, X.; Yan, J.; et al. Identification and characterization of Pestalotiopsis-like fungi related to grapevine diseases in China. Fungal Biol. 2015, 119, 348–361. [Google Scholar] [CrossRef] [PubMed]
- Ngadze, E.; Icishahayo, D.; Coutinho, T.A.; Van der Waals, J.E. Role of polyphenol oxidase, peroxidase, phenylalanine ammonia lyase, chlorogenic acid, and total soluble phenols in resistance of potatoes to soft rot. Plant Dis. 2012, 96, 186–192. [Google Scholar] [CrossRef] [PubMed]
- Feng, W.; Zheng, X.D.; Chen, J.P. Combined inhibitory effect against postharvest storage rots and their effects on postharvest quality parameters in cherry tomatoes by cassia oil and calcium chloride. J. Food Protect. 2013, 76, 1873–1878. [Google Scholar] [CrossRef]
- Cesarino, I.; Araujo, P.; Domingues Junior, A.P.; Mazzafera, P. An overview of lignin metabolism and its effect on biomass recalcitrance. Braz. J. Bot. 2012, 35, 303–311. [Google Scholar] [CrossRef]
- El-Samawaty, A.M.A. Inducing resistance in a flax cultivar susceptible to rust disease caused by Melampsora lini. J. Pure Appl. Microbio. 2013, 7, 1831–1836. [Google Scholar]
- El-Samawaty, A.M.A.; Yassin, M.A.; Moslem, M.A.; Omar, M.R. Role of some antioxidants in suppressing of flax powdery mildew. Fresen. Environ. Bull. 2016, 25, 1059–1067. [Google Scholar]

Publisher’s Note: MDPI stays neutral with regard to jurisdictional claims in published maps and institutional affiliations. |
© 2022 by the authors. Licensee MDPI, Basel, Switzerland. This article is an open access article distributed under the terms and conditions of the Creative Commons Attribution (CC BY) license (https://creativecommons.org/licenses/by/4.0/).
Share and Cite
Shi, T.; Pan, T.; Guo, M. First Isolation and Identification of Neopestalotiopsis clavispora Causing Postharvest Rot of Rosa sterilis and Its Control with Methyl Jasmonate and Calcium Chloride. Horticulturae 2022, 8, 190. https://doi.org/10.3390/horticulturae8030190
Shi T, Pan T, Guo M. First Isolation and Identification of Neopestalotiopsis clavispora Causing Postharvest Rot of Rosa sterilis and Its Control with Methyl Jasmonate and Calcium Chloride. Horticulturae. 2022; 8(3):190. https://doi.org/10.3390/horticulturae8030190
Chicago/Turabian StyleShi, Tingfeng, Tingtiao Pan, and Meiting Guo. 2022. "First Isolation and Identification of Neopestalotiopsis clavispora Causing Postharvest Rot of Rosa sterilis and Its Control with Methyl Jasmonate and Calcium Chloride" Horticulturae 8, no. 3: 190. https://doi.org/10.3390/horticulturae8030190
APA StyleShi, T., Pan, T., & Guo, M. (2022). First Isolation and Identification of Neopestalotiopsis clavispora Causing Postharvest Rot of Rosa sterilis and Its Control with Methyl Jasmonate and Calcium Chloride. Horticulturae, 8(3), 190. https://doi.org/10.3390/horticulturae8030190
